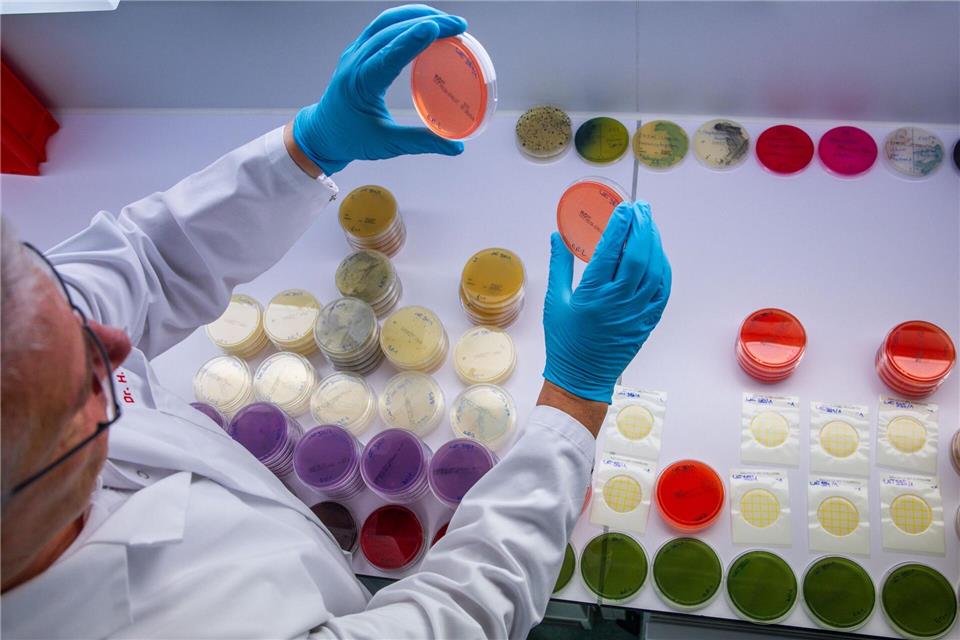

Wochenende im Norden zeigt sich mit Sonne und Wolken
Nach einem wolkigen Start mit gebietsweise Regen verspricht das Wochenende im Norden freundliches Wetter. Im Binnenland kann es nachts zu Frost kommen.

Das Wochenende im Norden wird freundlich mit einem Wechsel aus Sonne und Wolken. (Symbolbild)Jens Büttner/dpa
© Jens Büttner/dpa
Am Wochenende soll das Wetter im Norden überwiegend freundlich werden. Der Freitag startet aber erstmal bewölkt mit einzelnen Regenschauern bei Höchstwerten um die 12 Grad. Der Deutsche Wetterdienst (DWD) rechnet mit frischen Windböen an der Küste.
In der Nacht zum Samstag bleibt es zunächst wolkig mit gebietsweise Regen, bevor es auflockern soll. Die Tiefstwerte liegen bei etwa 7 Grad auf den Inseln und 3 Grad an der Küste. Im Binnenland wird bei bis zu 0 Grad leichter Frost erwartet. Der Samstag wird dann trocken und freundlich mit einem Wechsel aus Sonne und Wolken. Die Temperaturen klettern auf bis zu 13 Grad. Der Wind weht schwach, nur an der Küste Vorpommerns wird er böig.
Auch der Sonntag bleibt heiter und trocken
Laut DWD bleibt die Nacht zum Sonntag zunächst klar, nach Mitternacht können Wolken aufziehen. Die Tiefsttemperaturen sinken im Binnenland auf bis zu minus 3 Grad. An der Nord- und Ostsee liegen diese mit 2 und 5 Grad etwas höher. Auch der Sonntag bleibt mit Sonne und Wolken trocken. Es werden Maximalwerte um die 10 bis 12 Grad erwartet.